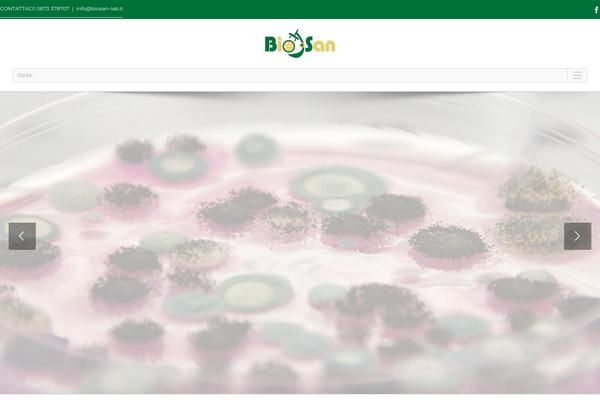

The list of WordPress websites with IT domain names
from 7000 to 7040 (23 508 sites available)
IT domain name is the country code top-level domain (ccTLD) for the Italy. WorpPress websites using the IT domain extension span a diverse range of categories and purposes, reflecting the broad spectrum of entities operating within the Italy.
Register domain names IT (Italy)
Anyone can certainly create WordPress website with domain names IT
Choose the best domain registration service for a WordPress website:
- Domain.com
- Namecheap
- GoDaddy
- Bluehost
- Name.com
- Web.com
Inspect popularity of domain zones for WP sites
.de (Germany)
.au (Australia)
.uk (United Kingdom)
.ca (Canada)
.it (Italy)
Domain zone popularity - updated statistical insights (only wordpress sites)